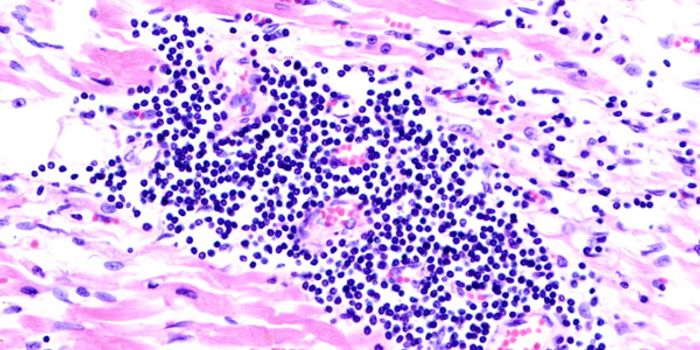
Single Cells to Thank for Rebuilding Blood Vessels

Endothelial Cells
Endothelium: refers to cells that line the interior surface of blood vessels and lymphatic vessels.
-
FEB 13, 2019ImmunologyA physical interaction between two types of immune cells that plays an essential role in the early fight against dengue ...Written By: Nicholas BreehlNOV 26, 2018CardiologyIf you’ve been drinking beet juice before going to the gym, the results of a new study may surprise you. Im ...Written By: Futurity (futurity.org)NOV 25, 2018MicrobiologyFirst identified in 1993, hantavirus infections can cause dangerous and potentially deadly respiratory infections.Written By: Carmen LeitchNOV 01, 2018Neurosciencemechanical changes in the blood vessels is communicated to brain via mechanosensitive Piezo ion channelsWritten By: Aswini KannegantiSEP 03, 2018NeuroscienceAir pollution is a problem that knows no geographical boundaries. When the World Health Organization studied the issue i ...Written By: Brenda Kelley KimAUG 08, 2018Drug Discovery & DevelopmentThe common form of tissue transplant is the corneal transplant. Corneal transplantation is performed to correct visual l ...Written By: Nouran AminJUL 22, 2018CardiologyProtein involved in blood vessel formation found to be higher in offspring of mothers who had gestational diabetes, hold ...Written By: Caitlin WilliamsJUN 20, 2018ImmunologySeveral immune cells help fungi infect the brain and cause meningitis when they should be doing the exact opposite. From ...Written By: Kara MarkerJUN 11, 2018ImmunologyThe immune response after a traumatic physical injury is essentially the same as a body-wide bacterial infection: inflam ...Written By: Kara MarkerMAY 09, 2018CardiologyDuring a process called angiogenesis, new blood vessels form as cells divide continuously to create new layers of tissue ...Written By: Kara MarkerAPR 25, 2018CardiologyThe same molecular pathway that is responsible for preventing adult heart cells from regenerating after being damaged - ...Written By: Kara MarkerAPR 17, 2018CancerNew research suggests polarity of tumor cells changes as part of the metastatic progression process and increases metast ...Written By: Mauri BrueggemanAPR 12, 2018CardiologyFor the first time, scientists are researching the link between mood, menopausal symptoms, quality of life, and vascular ...Written By: Kara MarkerAPR 10, 2018Clinical & Molecular DXTwo anti-cancer drugs are better than one, and the discovery of a new biomarker will likely help researchers identify th ...Written By: Kara MarkerMAR 15, 2018CancerDNA origami based nanostructures can sniff out tumor cellsWritten By:MAR 11, 2018Drug Discovery & DevelopmentMultiple sclerosis (MS) is a neurological disease that is unpredictable and often disabling in affected individuals. It ...Written By: Nouran AminFEB 20, 2018CardiologyMany types of heart disease and stroke stem from a poor supply of blood to important tissues and organs. A new discovery ...Written By: Kara MarkerJAN 25, 2018CardiologyWhen the heart deviates from its normal source of energy, congestive heart failure can develop. From the German Cancer R ...Written By: Kara MarkerJAN 16, 2018CardiologyA new treatment to be used in the wake of a heart attack is a little bit like putting a bandaid on a cut to prevent it f ...Written By: Kara MarkerJAN 12, 2018CardiologyA discovery arose from growing human arterial endothelial cells in the lab, and scientists from the Morgridge Institute ...Written By: Kara MarkerDEC 20, 2017Clinical & Molecular DXA cheap and commonly used diabetes drug may also treat and prevent preeclampsia. Preeclampsia is a medical condition tha ...DEC 19, 2017ImmunologyThere’s more to blood platelets than blood clotting, according to scientists from Ludwig-Maximilians-Universitat M ...Written By: Kara MarkerDEC 12, 2017CancerTime and time again, cancer has proven to be a most complex and formidable enemy. In many instances, cancer has outwitte ...NOV 18, 2017Drug Discovery & DevelopmentPSMA, currently used for successful in prostate cancer, is found to have potential utility for diagnostics and therapuet ...Written By: Courtney Schaal
FEB 13, 2019
Immunology
A physical interaction between two types of immune cells that plays an essential role in the early fight against dengue
...
Written By:
Nicholas Breehl
NOV 26, 2018
Cardiology
If you’ve been drinking beet juice before going to the gym, the results of a new study may surprise you. Im
...
Written By:
Futurity (futurity.org)
NOV 25, 2018
Microbiology
First identified in 1993, hantavirus infections can cause dangerous and potentially deadly respiratory infections.
Written By:
Carmen Leitch
NOV 01, 2018
Neuroscience
mechanical changes in the blood vessels is communicated to brain via mechanosensitive Piezo ion channels
Written By:
Aswini Kanneganti
SEP 03, 2018
Neuroscience
Air pollution is a problem that knows no geographical boundaries. When the World Health Organization studied the issue i
...
Written By:
Brenda Kelley Kim
AUG 08, 2018
Drug Discovery & Development
The common form of tissue transplant is the corneal transplant. Corneal transplantation is performed to correct visual l
...
Written By:
Nouran Amin
JUL 22, 2018
Cardiology
Protein involved in blood vessel formation found to be higher in offspring of mothers who had gestational diabetes, hold
...
Written By:
Caitlin Williams
JUN 20, 2018
Immunology
Several immune cells help fungi infect the brain and cause meningitis when they should be doing the exact opposite. From
...
Written By:
Kara Marker
JUN 11, 2018
Immunology
The immune response after a traumatic physical injury is essentially the same as a body-wide bacterial infection: inflam
...
Written By:
Kara Marker
MAY 09, 2018
Cardiology
During a process called angiogenesis, new blood vessels form as cells divide continuously to create new layers of tissue
...
Written By:
Kara Marker
APR 25, 2018
Cardiology
The same molecular pathway that is responsible for preventing adult heart cells from regenerating after being damaged -
...
Written By:
Kara Marker
APR 17, 2018
Cancer
New research suggests polarity of tumor cells changes as part of the metastatic progression process and increases metast
...
Written By:
Mauri Brueggeman
APR 12, 2018
Cardiology
For the first time, scientists are researching the link between mood, menopausal symptoms, quality of life, and vascular
...
Written By:
Kara Marker
APR 10, 2018
Clinical & Molecular DX
Two anti-cancer drugs are better than one, and the discovery of a new biomarker will likely help researchers identify th
...
Written By:
Kara Marker
MAR 15, 2018
Cancer
DNA origami based nanostructures can sniff out tumor cells
Written By:
MAR 11, 2018
Drug Discovery & Development
Multiple sclerosis (MS) is a neurological disease that is unpredictable and often disabling in affected individuals. It
...
Written By:
Nouran Amin
FEB 20, 2018
Cardiology
Many types of heart disease and stroke stem from a poor supply of blood to important tissues and organs. A new discovery
...
Written By:
Kara Marker
JAN 25, 2018
Cardiology
When the heart deviates from its normal source of energy, congestive heart failure can develop. From the German Cancer R
...
Written By:
Kara Marker
JAN 16, 2018
Cardiology
A new treatment to be used in the wake of a heart attack is a little bit like putting a bandaid on a cut to prevent it f
...
Written By:
Kara Marker
JAN 12, 2018
Cardiology
A discovery arose from growing human arterial endothelial cells in the lab, and scientists from the Morgridge Institute
...
Written By:
Kara Marker
DEC 20, 2017
Clinical & Molecular DX
A cheap and commonly used diabetes drug may also treat and prevent preeclampsia. Preeclampsia is a medical condition tha
...
DEC 19, 2017
Immunology
There’s more to blood platelets than blood clotting, according to scientists from Ludwig-Maximilians-Universitat M
...
Written By:
Kara Marker
DEC 12, 2017
Cancer
Time and time again, cancer has proven to be a most complex and formidable enemy. In many instances, cancer has outwitte
...
NOV 18, 2017
Drug Discovery & Development
PSMA, currently used for successful in prostate cancer, is found to have potential utility for diagnostics and therapuet
...
Written By:
Courtney Schaal